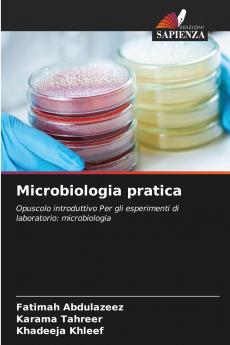
Microbiologia pratica
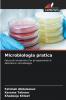
Microbiologia pratica

Italian
Paperback
₹5161
₹7127
27.59% OFF
(All inclusive*)
Delivery Options
Please enter pincode to check delivery time.
*COD & Shipping Charges may apply on certain items.
Review final details at checkout.
Looking to place a bulk order? SUBMIT DETAILS
Delivery Options
Please enter pincode to check delivery time.
*COD & Shipping Charges may apply on certain items.
Review final details at checkout.
About The Book
Description
Author(s)
Il libro è un manuale di laboratorio incentrato su esperimenti di microbiologia in particolare sull'identificazione e la caratterizzazione delle specie di Mycobacterium tra cui M. tuberculosis. Include vari test come il test del rosso neutro l'attività della catalasi la suscettibilità alla pirazinamide il test dell'amidasi e il test di riduzione dei nitrati che illustrano le proprietà biochimiche di questi batteri. Inoltre vengono illustrati i metodi di filtrazione dei batteri l'uso di disinfettanti come etanolo e isopropanolo e le radiazioni per la sterilizzazione. Nel complesso si tratta di una guida pratica per studenti e ricercatori di microbiologia.
Details
ISBN 13
9786208767549
Publication Date
-21-03-2025
Pages
-60
Weight
-95 grams
Dimensions
-152x229x3.65 mm